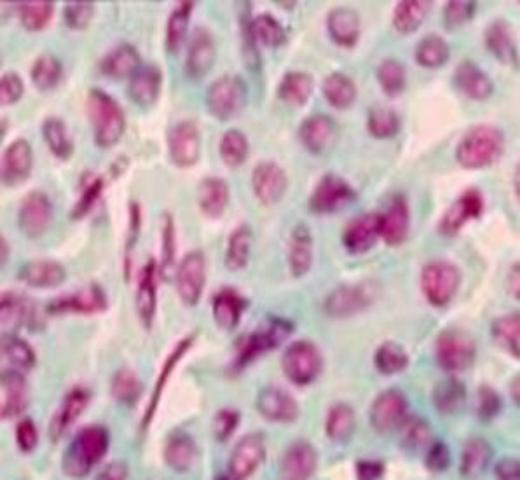
Fucsina

-
Willian Harvey concluye que las plantas y los animales se reproducen de forma sexual. "Esperma y huevos" es el orígen común de todos los seres vivos.
-
Antón van Leeuwenhoek (fabricante de lentes holandés, 1632-1723) fue probablemente la primera persona en observar bacterias (organismos unicelulares) y otros microorganismos. En 1674 observa protozoarios; en
1677 descubre los espermatozoides humanos y de otros animales (a los que llamó animáculos). Entusiastas practicantes de la microscopía durante esa época creyeron ver que un minúsculo homúnculo reside en el espermatozoide humano, reavivando antiguas creencias en preformacionismo de hac -
Gregor Johann Mendel (monje católico y naturalista austríaco, 1822-1884) establece en 1865 las
leyes de la herencia, fundando la disciplina científica de la Genética -
El médico alemán Walter Flemming fue el primero en investigar el proceso de la división celular, y la distribución de los cromosomas en el núcleo hermano. Denominó a este proceso mitosis, término derivado de la palabra griega mitos que significa hebra y se relaciona con la apariencia semejante a un filamento de los cromosomas condensados.
-
Richard Altmann, identifico a las nucleina como sustancias ácidas y las denomino con el nombre de ácidos nucleicos. Esta sustancia se encontró que sólo existen en los cromosomas.
-
El ADN fue aislado por Friederich Miescher en 1889, de esperma de salmón y de pus de heridas abiertas. Dado que lo encontró solamente en los núcleos Miescher denominó este compuesto nucleína. A posteriori se cambió a ácodo nucleico y por último a ácido desoxirriboneucleico.
-
El Alemán Correns, el austriacoTchermak y el holandés De Vries redescubren independientemente las leyes de Mendel. De Vries informa en 1901 por primera vez< de mutaciones.
-
William Batenson utiliza por primera vez la palabra "genética" para designar la ciencia dedicada al estudio de los fenómenos de la harencia y la variación
-
Wilhelm Joannsen estudia el término gen como expresión para los factores unitarios, que se ha demostrado que están en los gametos, por los investigadores modernos del "mendelismo".
-
Thomas Hunt Morgan demuestra que los genes residen en los cromosomas. Fue galardonado con el Premio Novel de Medicina en 1933 por ésta demostración.
-
Robert Feulgen en 1914, describió un método para revelar por tinción el ADN, basado en el colorante fucsina. Se encontró, utilizando este método, la presencia de ADN en el núcleo de todas las células eucariotas, específicamente en los cromosomas.
-
En 1919 el bioquímico ruso estadounidense Phoebus Levene indentificó que un nucleótido está formado por una base, un azúcar y un fosfato
-
En 1928 Frederick Griffith demostró que las bacterias eran capaces de transferir información genética mediante un proceso llamado transformación,
-
En 1930 Levene y su maestro Albrecht Kassel probaron que la nucleína de Miescher es un ácido desoxirriboneucleico formado por cuatro bases nitrogenadas, el azúcar desoxirribosa y un grupo fosfato.
-
En 1937 Willian Asbury produjo el primer patrón de difracción de rayos x que demostraba que el ADN tenias una estructura regular.
-
En 1940 Erwin Chargaff analizó las bases nitrogenadas del ADN en diferentes formas de vida, concluyendo que, la cantidad de purinas no siempre se encontraban en proporciones iguales a las de las pirimidinas (contrariamente a lo propuesto por Levene), la proporción era igual en todas las células de los individuos de una especie dada, pero variaba de una especie a otra
-
En 1944Oswald Theodore Avery, junto con su colaborador Maclyn McCarty, de que el ADN (ácido desoxiribonucleico) es el material del que los genes y los cromosomas están formados y de como estos definen la sexualidad del ser humano. Anteriormente se creía que eran la proteínas las portadoras de los genes.
-
Edwar Lawrie Tatun y George Wels Beadlemuestran que los genes codifican laa proteínas (enzimas)
-
Rosalind Franklin es recordada principalmente por la llamada Fotografía 51, la imagen del ADN obtenida mediante difracción de rayos X, que sirvió como fundamento para la hipótesis de la estructura doble helicoidal del ADN en la publicación del artículo de James Watson y Francis Crick de 1953
-
El biólogo estadounidense James Watson y el físico ingles Francis Crick propusieron el modelo de la deble hélice de ADN para representar la estructura tridimensional del polímero
-
En 1956 Vernon Ingras descubre que la anemia falciforme era causada por el cambio de un aminoácido en la henogllobina.
-
En 1975 el doctor argentino César Milstein y el doctor alemán George Kohler, del Laboratorio de Biología molecular de la Universidad de Cambridge decubrieron los anticuerpos.
-
En 1977 científicos norteamericanos introducen, por primera vez, en una bacteria material genético de células humanas.
-
En 1978 nace en Gran Bretaña el primer bebé probeta, engendrado mediante fertilización artificial o "in vitro"
-
En 1982 sale al mercado en Estasdos Unidos el primer medicamento producido por manipulación genética (la insulina).
-
En 1990 se inicia oficialmente El Proyecto Genoma Humano (PGH) con financiación estata, destinado a descifrar el código genético humano
-
En 1997 Investigadores escoceses presentaron a Dolly, una oveja, el primer mamífero producido por clonación a partir de una célula adulta.
-
El consorcio público internacional IRGSP (International Rice Genome Sequencing Project), en el que se integran investigadores de 10 países, ha dado a conocer la secuencia completa del genoma del arroz, el alimento básico para un tercio de la humanidad. La secuencia publicada puede ser clave no sólo para abordar mejoras en el arroz, sino también para conocer las características genéticas de otras especies veget
-
En 2002 nace en Argentina Pampa Mansa, la primera ternera clonada y transgénica que produce en su leche la hormona humana del crecimiento
-
En el 2007 se completa con éxito el Proyecto Genoma Humanocon el 99% del genoma secuenciado con una precisión del 99,99%
-
James Thompson y Shinya Yamanaka transforman células de la piel humana en células madre embrionarias.
Want to make a timeline like this?
Use Timetoast to turn dates, events, milestones, and phases into a clear visual timeline you can build and share. Timetoast is a timeline maker for work, school, research, and stories.